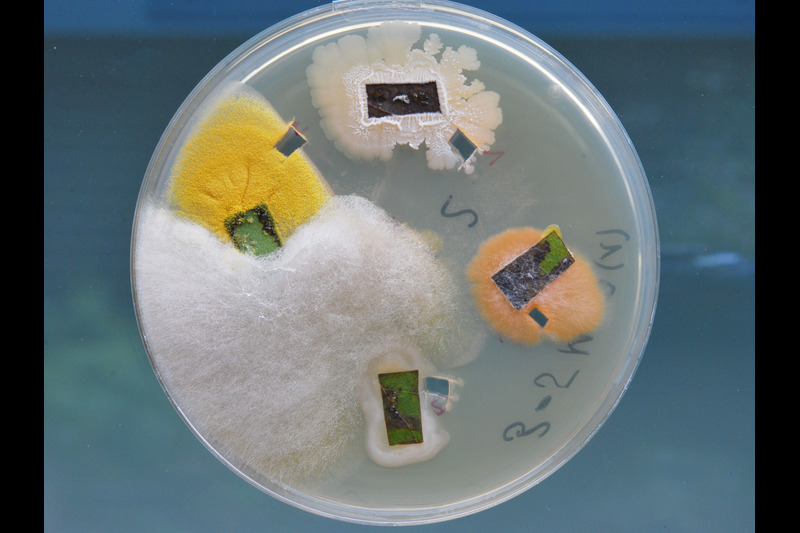

Entdeckung verborgener Verbündeter in Innovationsstrategien
Im Blattinneren lebende endophytische Pilze verstärken die chemische Abwehr von Schwarzpappeln und beeinflussen die Wechselwirkungen zwischen baumbesiedelnden Insektenpopulationen.
Forschende des Max-Planck-Instituts für chemische Ökologie und der Universität Kiel berichten in einer aktuellen Studie in der Fachzeitschrift Ecology Letters über den Einfluss eines endophytischen Pilzes der Gattung Cladosporium auf die Verteidigung von Schwarzpappeln gegen pflanzenfressende Insekten. Der im Blattinneren lebende Pilz steigert nicht nur die Produktion von Abwehrstoffen der Bäume, sondern produziert auch selbst ein Alkaloid, das die Bäume vor Fraßschäden schützt. Das Forschungsteam konnte darüber hinaus in Feldstudien zeigen, dass die Anwesenheit des Pilzes die Zusammensetzung der Insektengemeinschaften in jungen Schwarzpappeln beeinflusst. So scheiden auf den Bäumen lebende Blattläuse womöglich den Abwehrstoff des Pilzes in ihrem Honigtau aus und werden infolgedessen weniger von Ameisen besucht.
Endophyten: Freunde oder Feinde von Pflanzen
Sybille Unsicker
Christian-Albrechts-Universität zu Kiel
Endophyten sind Mikroorganismen, die im Inneren des Pflanzenkörpers leben. Einige dieser Lebewesen, meist Bakterien oder Pilze, machen die Pflanzen krank, andere haben keine schädlichen Auswirkungen auf die Pflanzen oder sind sogar nützlich. Frühere Untersuchungen an endophytischen Pilzen, die im Inneren bestimmter Gräser leben, haben bereits gezeigt, dass diese Pilze die Gräser mit Abwehrstoffen gegen Fraßfeinde versorgen. Ob dies auch für Bäume gilt, wurde bisher eher selten beobachtet. Die aktuelle Studie untersuchte nun den Einfluss eines endophytischen Pilzes der Gattung Cladosporium auf die Abwehr von Fraßfeinden der Schwarzpappel Populus nigra sowie die Auswirkungen auf die Insektengemeinschaften der Pappeln.
„Wir untersuchten den Einfluss des Endophyten auf die chemische Verteidigung von Schwarzpappeln und die Folgen für die Nahrungspräferenz und Fitness pflanzenfressender Insekten sowie die Zusammensetzung der Insektengemeinschaft an jungen Bäumen im Freiland. Aus früheren Studien wussten wir bereits, dass pflanzenpathogene Rostpilze pflanzenfressenden Insekten Vorteile bringen. Nun interessierten wir uns für einen endophytischen Pilz, dessen Rolle in der Pappel-Insekten-Interaktion noch weitgehend unerforscht ist“, erläutert Erstautorin Christin Walther den Ausgangspunkt der Studie.
Die Forschenden fanden heraus, dass die Besiedlung mit dem pilzlichen Endophyten die natürliche und die durch Insektenfraß ausgelöste Abwehr der Pappeln verstärkt. In Laborversuchen bevorzugten die Larven des Schwammspinners Lymantria dispar, eines Generalisten auf verschiedenen Bäumen, nicht infizierte Blätter und entwickelten sich dort besser. „Wir konnten zeigen, dass Cladosporium der Pflanze hilft, sich gegen Fraßfeinde zu verteidigen. Dazu verändert der Pilz das chemische Abwehrprofil der Pflanze und unterstützt es zusätzlich mit einem selbst produzierten Abwehrstoff“, sagt Christin Walther.
Mit Hilfe modernster chemisch-analytischer Methoden, dem sogenannten Metabolomics-Ansatz, bei dem die Stoffwechselprodukte in den Blättern analysiert wird, konnten die Wissenschaftlerinnen zeigen, dass eine Infektion mit dem Pilz das Metabolom der Pappel, also die in der Pappel gebildeten Substanzen, verändert. Spezifische Abwehrstoffe wie Salicinoide (Salicin, Nigracin) und phenolische Säuren (Kaffeesäure) wurden in Gegenwart des Pilzes vermehrt gebildet. Salicinoide sind zusammen mit Tanninen die wichtigsten natürlichen Abwehrstoffe, die Pappeln produzieren, um sich zu schützen. Besonders gut wirken Salicinoide gegen Insekten, die nicht nur auf Pappeln spezialisiert sind, sondern auch Schädlinge an anderen Pflanzen sind. Sie schrecken Schadinsekten nicht nur ab, sondern beeinflussen auch die Fitness von Insekten, die an chemisch verteidigten Blättern fressen, negativ.
Cladosporium verteidigt Pappeln mit einem eigenen Abwehrstoff
Die Analyse ergab, dass ein wirksamer Abwehrstoff, das Alkaloid Stachydrin, vom Pilz selbst gebildet wird. Versuche mit Stachydrin zeigten, dass der Wirkstoff aus dem Endophyten sowohl Generalisten wie den Bürstenspinner Orgyia antiqua als auch Pappel-Spezialisten wie den Pappelblattkäfer Chrysomela tremulae abschreckt.
„Für uns war es besonders spannend zu sehen, dass der Pilz ein Alkaloid produzieren kann, das wir in der Pflanzenmatrix nachweisen und so als Marker für die Anwesenheit des Pilzes nutzen können. Sogar in den Blättern alter Bäume im Freiland fanden wir diese Substanz“, sagt Studienleiterin Sybille Unsicker, die am Max-Planck-Institut für chemische Ökologie die Arbeitsgruppe „Pflanze-Umwelt-Interaktionen“ leitete und seit 2023 Professorin an der Christian-Albrechts-Universität zu Kiel ist.
Kombination von chemischen Analysen, Verhaltensexperimenten und Freilanduntersuchungen
Die Wissenschaftlerinnen verfolgten einen ganzheitlichen Forschungsansatz. Neben chemischen Analysen von Laborpflanzen mit und ohne den endophytischen Pilz und den damit verbundenen Fraßexperimenten untersuchten sie im Freiland, wie Cladosporium die chemische Ökologie von Schwarzpappeln beeinflusst.
Ein weiteres interessantes Ergebnis dieser Studie ist daher eine Beobachtung, die die Forschenden in Freilanduntersuchungen gemacht haben. Der endophytische Pilz scheint auch die Interaktionen zwischen Blattläusen und Ameisen zu verändern, die junge Schwarzpappeln besiedeln. Es handelt sich um einen Mutualismus, eine Symbiose, von der sowohl die Ameisen profitieren, die den Honigtau der Blattläuse trinken, als auch die Blattläuse, die von den Ameisen vor Fressfeinden geschützt werden. Pflanzen, die zuvor mit dem Endophyten infiziert worden waren, wurden häufiger von Blattläusen, aber weniger von Ameisen besiedelt. Dies ist wahrscheinlich auf die Konzentration von Stachydrin in ihrem Honigtau zurückzuführen. „Der Pilz scheint sogar in der Lage zu sein, eine mutualistische Beziehung zwischen Ameisen und Blattläusen zu manipulieren. Was hier genau passiert, müssen nun weitere Untersuchungen klären“, sagt Christin Walther.
Bäume sind Metaorganismen
Die Erforschung des Mikrobioms eines Baumes, also der Gesamtheit der Mikroorganismen, mit denen der Baum vergesellschaftet ist, ist wichtig, um die Komplexität der Koevolution von Bäumen und anderen Lebewesen, mit denen sie in Wechselwirkung stehen, zu verstehen. Die aktuelle Studie ist erst der Anfang eines breiten Forschungsfeldes, das viele weitere spannende Fragen aufwirft. So sollen weitere Untersuchungen klären, wie sich der Pilz in der Pflanze ausbreitet und ob er die Pflanze nicht nur vor Insektenfraß, sondern möglicherweise auch vor Krankheitserregern schützt. Interessant ist auch die Frage, ob es sich bei der Beziehung zwischen Schwarzpappel und Cladosporium um eine Symbiose handelt und der Pilz umgekehrt vom Zusammenleben mit dem Baum profitiert, oder ob es Bedingungen gibt, unter denen er vom Partner zur Bedrohung für den Baum wird.
„Immer mehr Fakten sprechen dafür, Bäume als Holobionten zu betrachten, als eine Gemeinschaft verschiedener Lebewesen. Ein Baum ist nie ein einzelnes Individuum, sondern ein komplexer Metaorganismus, der in allen seinen Organen von Mikroorganismen und Arthropoden besiedelt ist. Für uns stellt sich die spannende Frage, welchen Beitrag die Mikroorganismen zur Koevolution von Bäumen und pflanzenfressenden Insekten leisten. Unsere Ergebnisse sind sicher nur ein kleiner Beitrag zum Verständnis dieser komplexen Wechselwirkungen“, resümiert Sybille Unsicker.
Contact for scientific information:
Prof. Dr. Sybille Unsicker, Plant-Environment-Interactions Group, Botanisches Institut, Christian-Albrechts-Universität zu Kiel, Am Botanischen Garten 5, D-24118 Kiel, Tel: +49 431 880-4240, E-Mail: sunsicker@bot.uni-kiel.de
Dr. Christin Walther, Plant-Environment-Interactions Group, Botanisches Institut, Christian-Albrechts-Universität zu Kiel, Am Botanischen Garten 5, D-24118 Kiel, Tel: +49 431 880-4239, E-Mail: cwalther@bot.uni-kiel.de
Original publication:
Christin Walther, Marine Vallet, Michael Reichelt, Prajakta Giri, Beate Rothe, Elina J. Negwer, Pamela Medina van Berkum, Jonathan Gershenzon, Sybille B. Unsicker
Fachzeitschrift: Ecology Letters
Titel des Artikels: A Fungal Endophyte Alters Poplar Leaf Chemistry, Deters Insect Feeding and Shapes Insect Community Assembly
Veröffentlichungsdatum des Artikels: 26 February 2025
DOI: https://doi.org/10.1111/ele.70007
More information:
https://www.ice.mpg.de/218452/chemical-ecology-in-poplar Projektgruppe Pflanze-Umwelt-Interaktionen am Max-Planck-Institut für chemische Ökologie
Presse
Angela Overmeyer
Telephone: 03641 572110
fax: 03641 571002
email address: overmeyer@ice.mpg.de
Source: IDW




